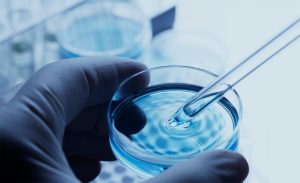

بررسی خواص، مزایا و تاریخچه ترموپلاستیک الاستومرها (TPE – Thermoplastic elastomer)
ترموپلاستیک الاستومرها (TPE) چیست؟ ترموپلاستیک الاستومرها (TPEs) دسته ای از مواد هستند که خواص مطلوب ترموپلاستیک ها و الاستومرها را ترکیب می کنند. آنها دارای
Type and hit enter
Import & Export Chemicals Raw Materials
شرکت پایا فام پارس با بیش از 10 سال سابقه تجارت بین الملل و با بهره گیری از متخصصان و کارشناسان خبره عرصه تجارت بین الملل و استفاده از متخصصین تراز اول صنایع رنگ، رزین، چسب و کامپوزیت در کشور مفتخر است مواد اولیه حیاتی صنایع مربوطه را از بهترین تولید کنندگان خارجی از کشورهای آلمان، ژاپن و کره جنوبی حتی در شرایط تحریم به کشور وارد و با قیمت های رقابتی در کنار پشتیبانی فنی تیم R&D خود در اختیار تولید کنندگان محترم گذارد. عمده محصولات این شرکت شامل مواد اولیه صنایع چسب گرما ذوب و مواد اولیه صنایع رنگ و رزین های صنعتی الخصوص در زمینه رزین ها و هاردنر های اپوکسی است.
شرکت پایا فام پارس مفتخر است در سه زمینه متفاوت
– فروش مواد اولیه به صورت ریالی و پیش فروش انواع کالاهای وارداتی
– مشاوره و مدیریت نوسانات قیمت های داخلی و خارجی با توجه به وضعیت بازارهای بین الملل
– پشتیبانی و خدمات فنی استفاده از محصولات شرکت و رفع مشکلات تولید
در خدمت مشتریان و تولید کنندگان محترم رنگ، رزین، چسب و کامپوزیت کشور باشد.
کیفیت را با پایا فام پارس تجربه کنید
شما میتوانید مقالات پر بازدید و تخصصی را در این قسمت مطالعه نمایید

ترموپلاستیک الاستومرها (TPE) چیست؟ ترموپلاستیک الاستومرها (TPEs) دسته ای از مواد هستند که خواص مطلوب ترموپلاستیک ها و الاستومرها را ترکیب می کنند. آنها دارای

رزین های اکریلیک چیست؟ در قلمرو مواد مدرن، رزین های اکریلیک به عنوان ترکیبی جذاب از وضوح، تطبیق پذیری، و توانایی ثبت رنگ های زنده

رزین های وینیل استر چیست؟ در حوزه مواد کامپوزیتی پیشرفته، رزینهای وینیل استر به عنوان یک کلاس پویا برجسته میشوند که بهترینهای دو جهان را

رزین های فنولیک چیست؟ در پلیمرها، رزین های فنولیک به دلیل تطبیق پذیری قابل توجه خود متمایز هستند. برای بیش از یک قرن، این رزین

رزین های پلی استر چیست؟ در علم مواد مدرن، رزین های پلی استر به عنوان ترکیبات پویا و همه کاره ظاهر شده اند و نقشی
رزین های پلی یورتان چیست؟ در قلمرو علم مواد مدرن، مواد کمی تطبیق پذیری قابل توجه و پتانسیل تبدیل بالای رزین های پلی یورتان را
شما میتوانید اخبار مهم شرکت پایافام پارس و ایران را در این قسمت مطالعه نمایید

معرفی نوروز : نوروز جشن بهاری و آغاز سال نو در ایران، افغانستان، تاجیکستان، آذربایجان، کردستان و برخی کشورهای دیگری است که با فرا رسیدن

بر خلاف وعده های وزیر اقتصاد بهای دلار در بازار آزاد ایران افزایش داشت و دلار از مرز 44 هزار تومان نیز فراتر رفت و

وزارت اقتصاد در پاسخ به گزارش ۱۹ دی ماه روزنامه اعتماد با عنوان «وزیر و وکیل علیه ارزِ رییس»، گزارش روزنامه مردم سالاری با عنوان

عباس هاشمی در گفتوگو با ایسنا با بیان اینکه نرخ ارز یکی از فاکتورهای تولید است، اظهار کرد: تثبیت نرخ روی ۲۸ هزار و ۵۰۰

پس از جهش ارزی در ابتدای دهه 1390، تا سال 1396 متوسط رشد سالانه نرخ ارز در سطحی پایینتر از دهه 1370 قرار داشته و

به گزارش جام جم به نقل از روابط عمومی وزارت صمت، سید رضا فاطمی امین در آخرین روز از اجلاس دو روزه رؤسای دانشگاهها، پژوهشگاهها و پارکهای
برای دانلود اطلاعات محصول لطفا نام و شماره همراه خود را وارد نمایید.
افزودن {{itemName}} به سبد خرید
افزودن {{itemName}} به سبد خرید